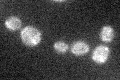
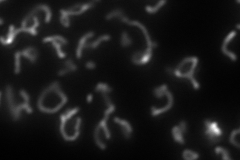
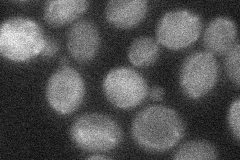
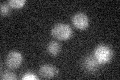

View description
Copper-binding protein of the mitochondrial inner membrane, required for cytochrome c oxidase activity and respiration; may function to deliver copper to cytochrome c oxidase; has similarity to thioredoxins
Localization:
Intensity:
Fold change:
Significance:
-
C’ GFP library in SD
mitochondria18.31 -
N' NOP1pr-GFP in SD

mitochondria67.5615 -
N' TEF2pr-mCherry in SD
mitochondria41.0355 -
N' NATIVEpr-GFP in SD
cytosol,mitochondria24.4882 -
N' TEF2pr-VC and Cyto-VN in SD

#N/A0 -
C’ GFP library in SD+DTT

mitochondria16.970.92No -
C’ GFP library in SD+H2O2

mitochondria16.50.9No -
C’ GFP library in Starvation Media
mitochondria22.121.2No -
C’ GFP library on the background of Pup2-DaMP

mitochondria -
C’ GFP library on the background of CCT mutant

mitochondria15.90180.867929No
